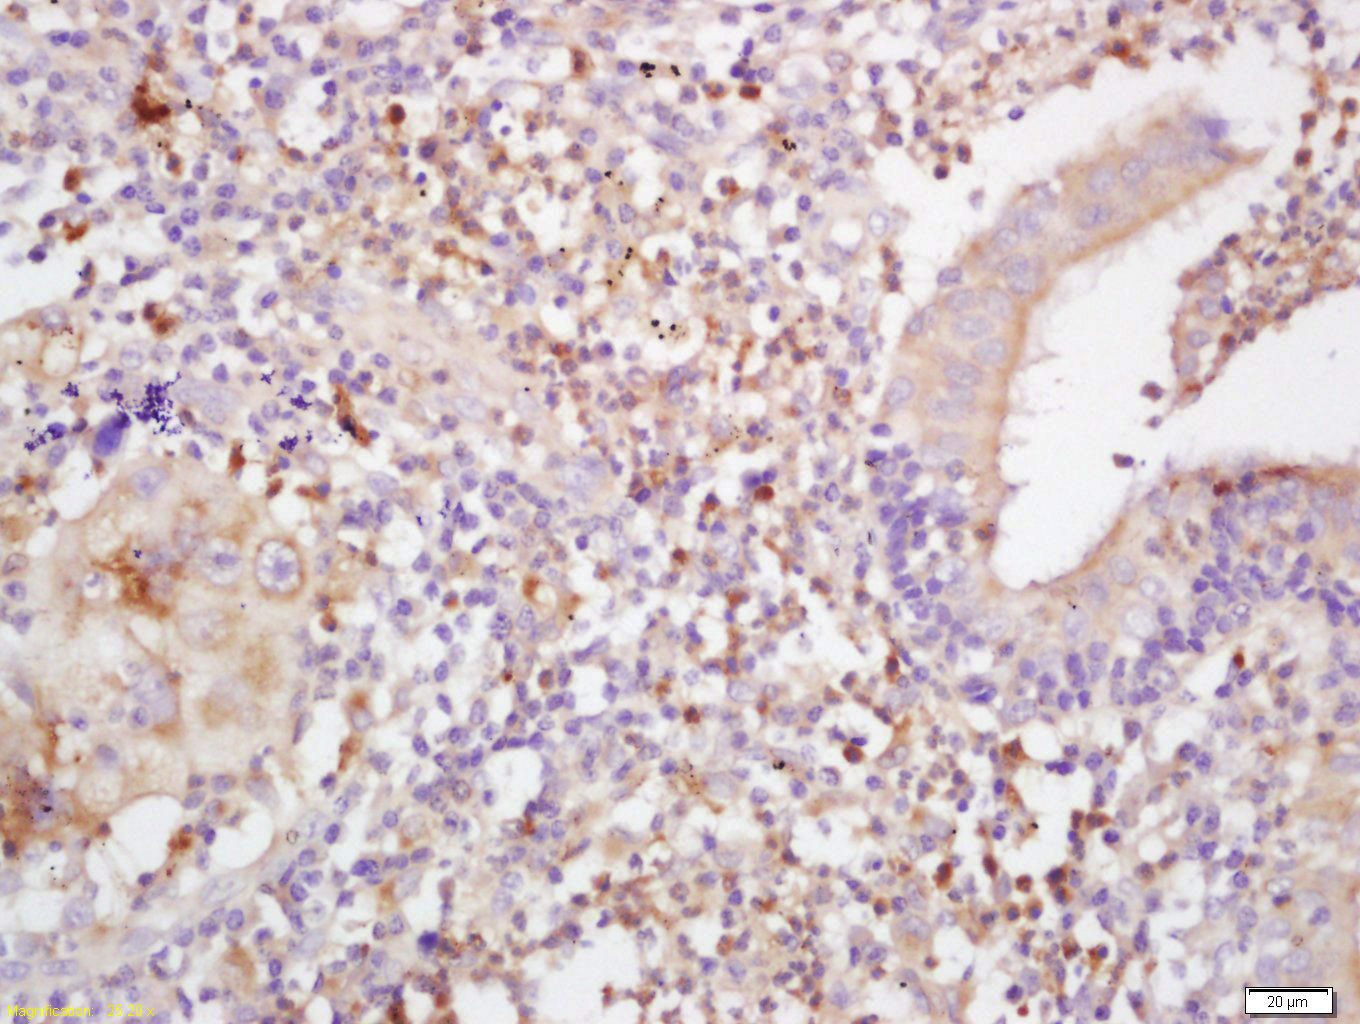

HLA-C Rabbit pAb
HLA-C Rabbit pAb
- 产品详情
- 实验流程
- 背景知识
Application
| IHC-P, IHC-F, IF |
|---|---|
| Primary Accession | P10321 |
| Host | Rabbit |
| Clonality | Polyclonal |
| Calculated MW | 40649 Da |
| Physical State | Liquid |
| Immunogen | KLH conjugated synthetic peptide derived from human HLA-C |
| Epitope Specificity | 81-180/366 |
| Isotype | IgG |
| Purity | affinity purified by Protein A |
| Buffer | 0.01M TBS (pH7.4) with 1% BSA, 0.02% Proclin300 and 50% Glycerol. |
| SUBCELLULAR LOCATION | Cell Membrane; Type I membrane protein. |
| SIMILARITY | Belongs to the MHC class I family.Contains 1 Ig-like C1-type (immunoglobulin-like) domain. |
| SUBUNIT | Heterodimer of an alpha chain and a beta chain (beta-2-microglobulin). Interacts with human herpesvirus 8 MIR1 protein. Interacts with HTLV-1 p12I accessory protein. |
| Post-translational modifications | N-linked glycosylation at Asn-110 is required for efficient interaction with CANX and CALR chaperones and appropriate HLA-C-B2M folded conformers prior to peptide loading |
| Important Note | This product as supplied is intended for research use only, not for use in human, therapeutic or diagnostic applications. |
| Background Descriptions | HLA-C belongs to the HLA class I heavy chain paralogues. This class I molecule is a heterodimer consisting of a heavy chain and a light chain (beta-2 microglobulin). The heavy chain is anchored in the membrane. Class I molecules play a central role in the immune system by presenting peptides derived from endoplasmic reticulum lumen. They are expressed in nearly all cells. The heavy chain is approximately 45 kDa and its gene contains 8 exons. Exon one encodes the leader peptide, exons 2 and 3 encode the alpha1 and alpha2 domain, which both bind the peptide, exon 4 encodes the alpha3 domain, exon 5 encodes the transmembrane region, and exons 6 and 7 encode the cytoplasmic tail. Polymorphisms within exon 2 and exon 3 are responsible for the peptide binding specificity of each class one molecule. Typing for these polymorphisms is routinely done for bone marrow and kidney transplantation. About 6000 HLA-C alleles have been described. The HLA system plays an important role in the occurrence and outcome of infectious diseases, including those caused by the malaria parasite, the human immunodeficiency virus (HIV), and the severe acute respiratory syndrome coronavirus (SARS-CoV). The structural spike and the nucleocapsid proteins of the novel coronavirus SARS-CoV-2, which causes coronavirus disease 2019 (COVID-19), are reported to contain multiple Class I epitopes with predicted HLA restrictions. Individual HLA genetic variation may help explain different immune responses to a virus across a population.[provided by RefSeq, Aug 2020] |
| Gene ID | 3107 |
|---|---|
| Other Names | HLA class I histocompatibility antigen, C alpha chain, HLA-C, HLA-Cw, Human leukocyte antigen C, HLA-C (HGNC:4933), HLAC |
| Dilution | IHC-P=1:100-500,IHC-F=1:100-500,IF=1:100-500 |
| Storage | Store at -20 °C for one year. Avoid repeated freeze/thaw cycles. When reconstituted in sterile pH 7.4 0.01M PBS or diluent of antibody the antibody is stable for at least two weeks at 2-4 °C. |
| Name | HLA-C (HGNC:4933) |
|---|---|
| Synonyms | HLAC |
| Function | Antigen-presenting major histocompatibility complex class I (MHCI) molecule with an important role in reproduction and antiviral immunity (PubMed:11172028, PubMed:20104487, PubMed:20439706, PubMed:20972337, PubMed:24091323, PubMed:28649982, PubMed:29312307). In complex with B2M/beta 2 microglobulin displays a restricted repertoire of self and viral peptides and acts as a dominant ligand for inhibitory and activating killer immunoglobulin receptors (KIRs) expressed on NK cells (PubMed:16141329). In an allogeneic setting, such as during pregnancy, mediates interaction of extravillous trophoblasts with KIR on uterine NK cells and regulate trophoblast invasion necessary for placentation and overall fetal growth (PubMed:20972337, PubMed:24091323). During viral infection, may present viral peptides with low affinity for KIRs, impeding KIR-mediated inhibition through peptide antagonism and favoring lysis of infected cells (PubMed:20439706). Presents a restricted repertoire of viral peptides on antigen-presenting cells for recognition by alpha-beta T cell receptor (TCR) on HLA-C-restricted CD8-positive T cells, guiding antigen-specific T cell immune response to eliminate infected cells, particularly in chronic viral infection settings such as HIV-1 or CMV infection (PubMed:11172028, PubMed:20104487, PubMed:28649982). Both the peptide and the MHC molecule are recognized by TCR, the peptide is responsible for the fine specificity of antigen recognition and MHC residues account for the MHC restriction of T cells (By similarity). Typically presents intracellular peptide antigens of 9 amino acids that arise from cytosolic proteolysis via proteasome. Can bind different peptides containing allele-specific binding motifs, which are mainly defined by anchor residues at position 2 and 9. Preferentially displays peptides having a restricted repertoire of hydrophobic or aromatic amino acids (Phe, Ile, Leu, Met, Val and Tyr) at the C-terminal anchor (PubMed:25311805, PubMed:8265661). |
| Cellular Location | Cell membrane; Single-pass type I membrane protein. Endoplasmic reticulum membrane; Single-pass membrane protein |
| Tissue Location | Ubiquitous. Highly expressed in fetal extravillous trophoblasts in the decidua basalis (at protein level) |
For Research Use Only. Not For Use In Diagnostic Procedures.
Provided below are standard protocols that you may find useful for product applications.
BACKGROUND
HLA-C belongs to the HLA class I heavy chain paralogues. This class I molecule is a heterodimer consisting of a heavy chain and a light chain (beta-2 microglobulin). The heavy chain is anchored in the membrane. Class I molecules play a central role in the immune system by presenting peptides derived from endoplasmic reticulum lumen. They are expressed in nearly all cells. The heavy chain is approximately 45 kDa and its gene contains 8 exons. Exon one encodes the leader peptide, exons 2 and 3 encode the alpha1 and alpha2 domain, which both bind the peptide, exon 4 encodes the alpha3 domain, exon 5 encodes the transmembrane region, and exons 6 and 7 encode the cytoplasmic tail. Polymorphisms within exon 2 and exon 3 are responsible for the peptide binding specificity of each class one molecule. Typing for these polymorphisms is routinely done for bone marrow and kidney transplantation. About 6000 HLA-C alleles have been described. The HLA system plays an important role in the occurrence and outcome of infectious diseases, including those caused by the malaria parasite, the human immunodeficiency virus (HIV), and the severe acute respiratory syndrome coronavirus (SARS-CoV). The structural spike and the nucleocapsid proteins of the novel coronavirus SARS-CoV-2, which causes coronavirus disease 2019 (COVID-19), are reported to contain multiple Class I epitopes with predicted HLA restrictions. Individual HLA genetic variation may help explain different immune responses to a virus across a population.[provided by RefSeq, Aug 2020]
终于等到您。ABCEPTA(百远生物)抗体产品。
点击下方“我要评价 ”按钮提交您的反馈信息,您的反馈和评价是我们最宝贵的财富之一,
我们将在1-3个工作日内处理您的反馈信息。
如有疑问,联系:0512-88856768 tech-china@abcepta.com.























 癌症的基本特征包括细胞增殖、血管生成、迁移、凋亡逃避机制和细胞永生等。找到癌症发生过程中这些通路的关键标记物和对应的抗体用于检测至关重要。
癌症的基本特征包括细胞增殖、血管生成、迁移、凋亡逃避机制和细胞永生等。找到癌症发生过程中这些通路的关键标记物和对应的抗体用于检测至关重要。 为您推荐一个泛素化位点预测神器——泛素化分析工具,可以为您的蛋白的泛素化位点作出预测和评分。
为您推荐一个泛素化位点预测神器——泛素化分析工具,可以为您的蛋白的泛素化位点作出预测和评分。 细胞自噬受体图形绘图工具为你的蛋白的细胞受体结合位点作出预测和评分,识别结合到自噬通路中的蛋白是非常重要的,便于让我们理解自噬在正常生理、病理过程中的作用,如发育、细胞分化、神经退化性疾病、压力条件下、感染和癌症。
细胞自噬受体图形绘图工具为你的蛋白的细胞受体结合位点作出预测和评分,识别结合到自噬通路中的蛋白是非常重要的,便于让我们理解自噬在正常生理、病理过程中的作用,如发育、细胞分化、神经退化性疾病、压力条件下、感染和癌症。